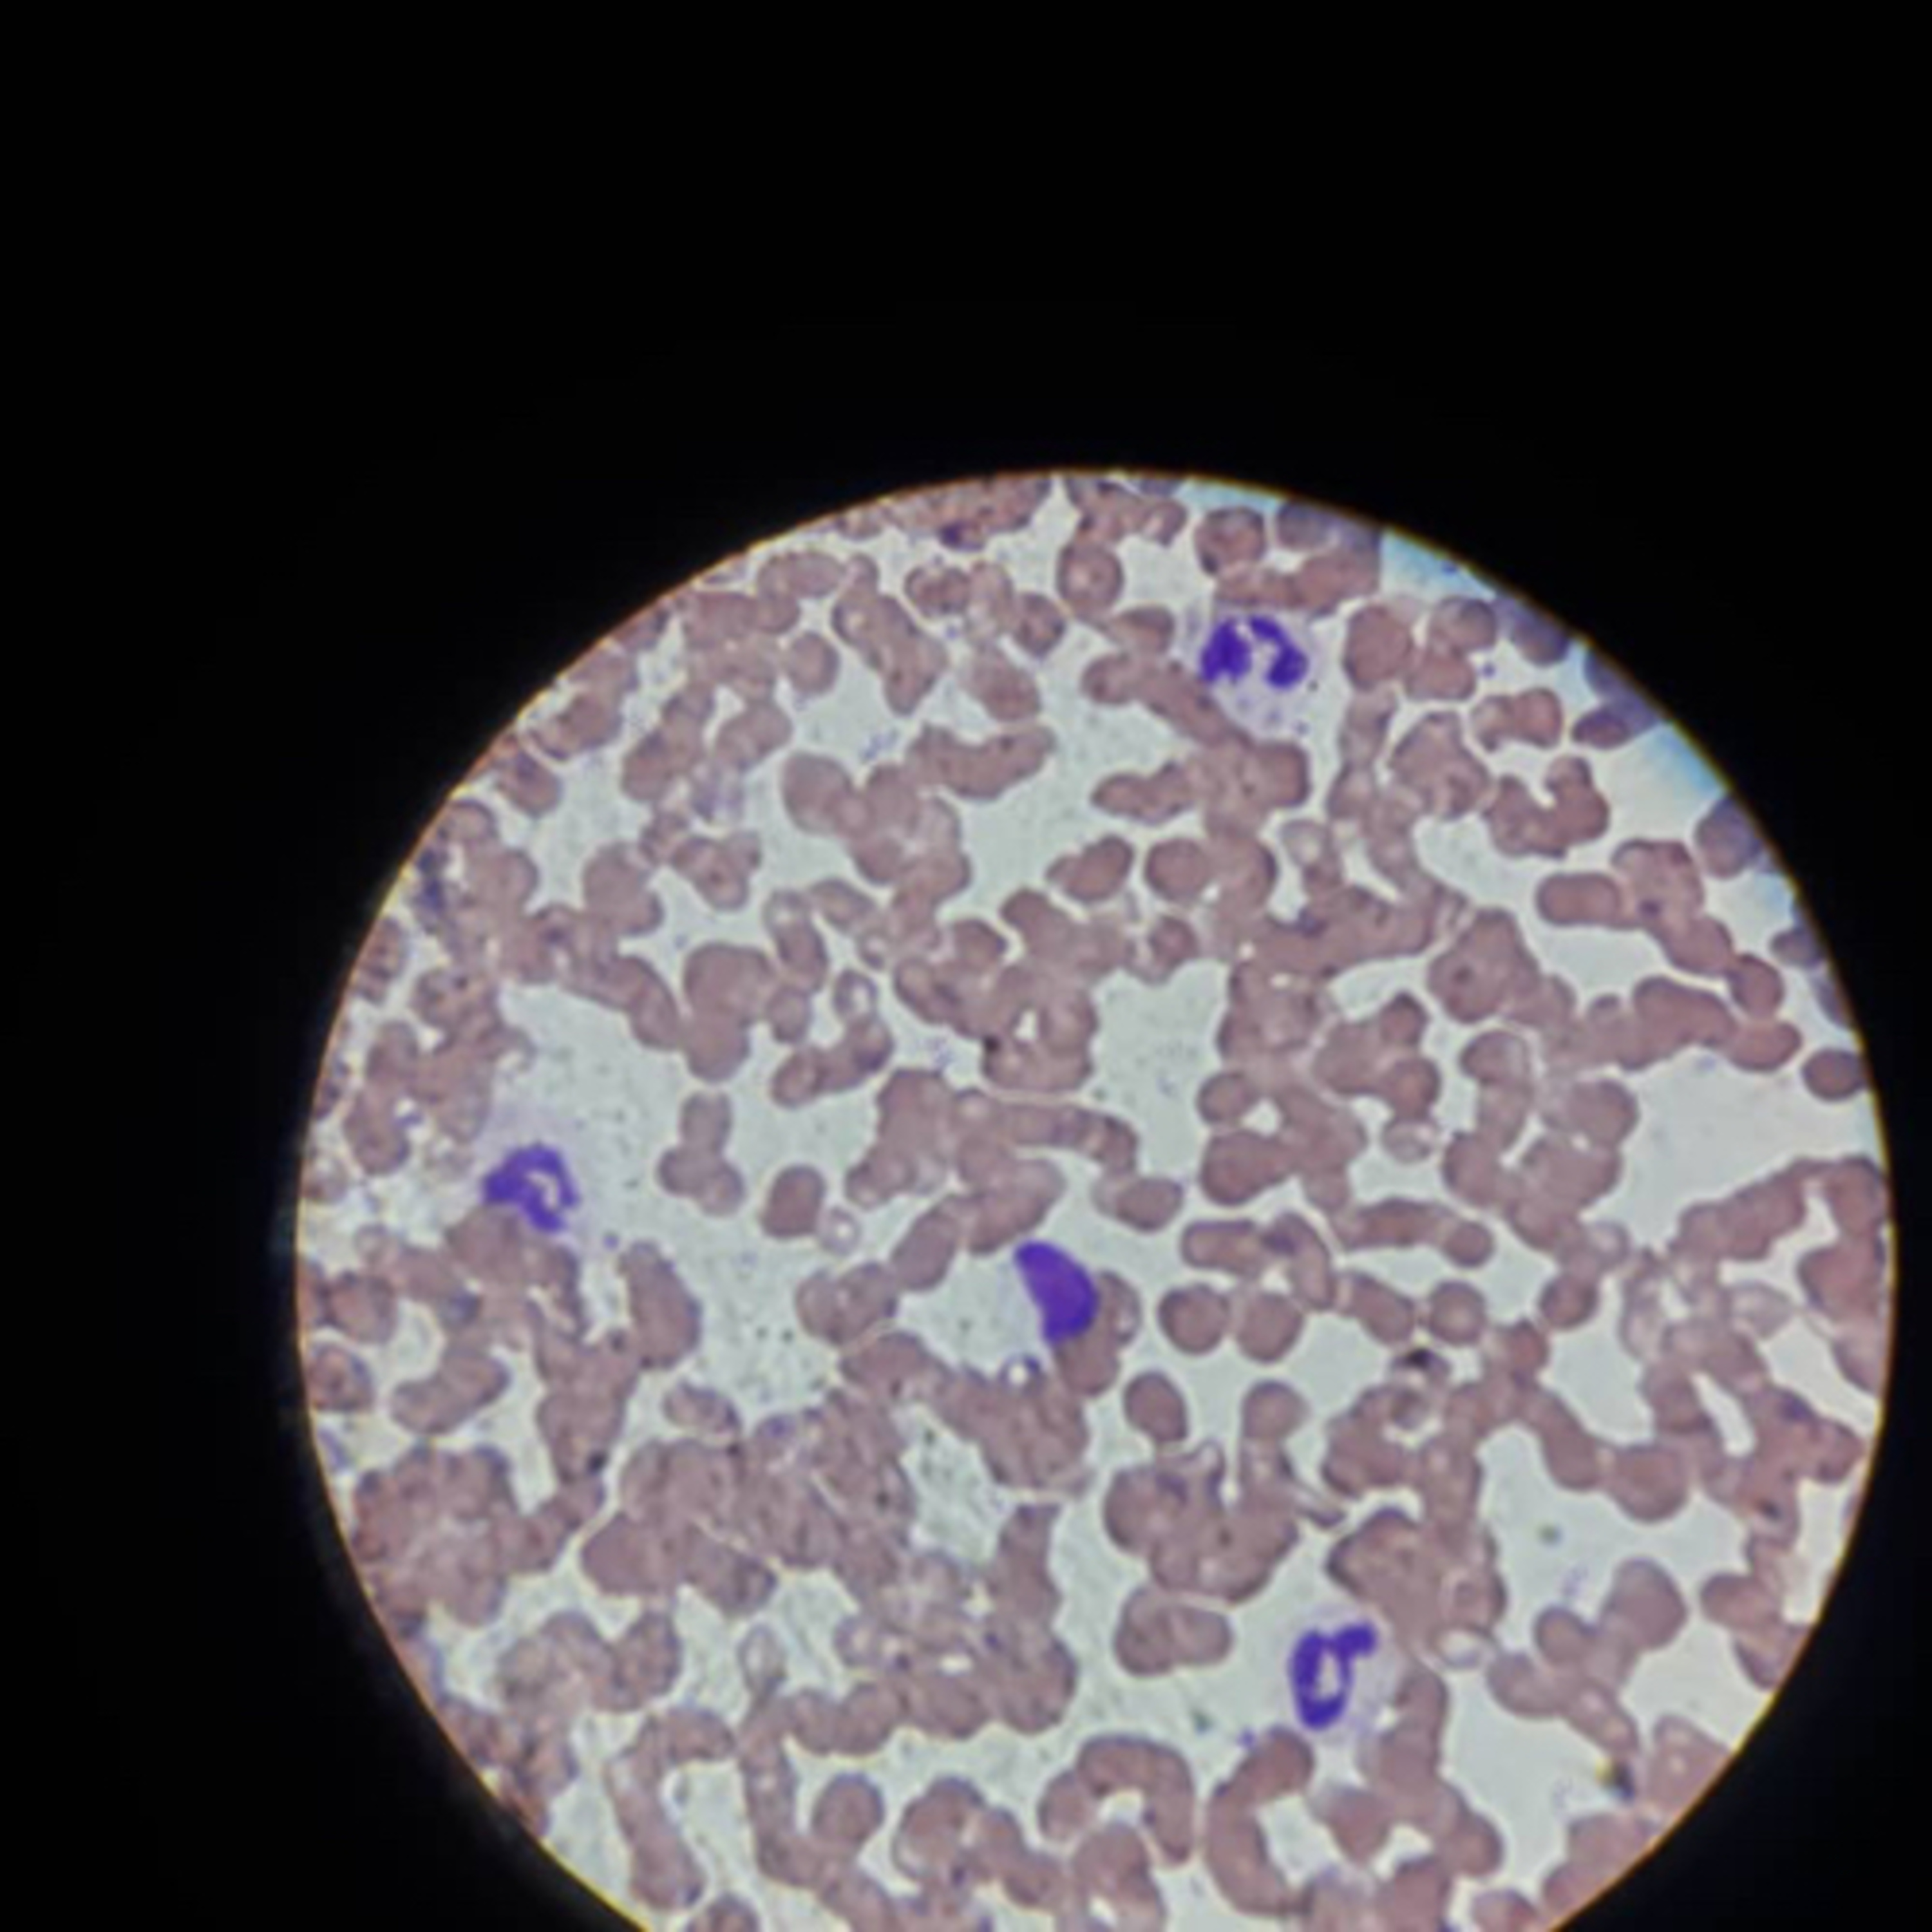

![]() |
Chapters of LifeAuthor: Austin Mudd Language: en-us Genres: Health & Fitness, Medicine Contact email: Get it Feed URL: Get it iTunes ID: Get it |
Listen Now...
Military Appreciation Month: Supporting Our Service Members
Episode 5
Thursday, 30 May, 2024
As Military Appreciation Month winds to a close in May, John Hillery, the Commander of the Military Oder of the Purple Heart in Lakeland, Florida and Clifton Pease, the Chapters Health Valor Program Services Manager, joins the Chapters of Life Podcast to discuss how their organizations and others in the community are supporting and showing appreciation to military service members. If you are a caregiver or passionate about chronic illness care and have a topic idea for the podcast or would like to provide feedback, feel free to reach out at socialmedia@chaptershealth.org.Follow us:Chapters Health System website: https://www.chaptershealth.org/Facebook : https://www.facebook.com/ChaptersHealthLinkedIn : https://www.linkedin.com/company/chapters-health-system/X: https://twitter.com/Chapters_HealthInstagram: https://www.instagram.com/chaptershealthsystemTiktok: @ChaptersHealthSystemPinterest: https://www.pinterest.com/chaptershealthIf you are a caregiver or passionate about chronic illness care and have a topic idea for the podcast or would like to provide feedback, feel free to reach out at socialmedia@chaptershealth.org.Follow us:Chapters Health System website: https://www.chaptershealth.org/Facebook : https://www.facebook.com/ChaptersHealthLinkedIn : https://www.linkedin.com/company/chapters-health-system/Twitter: https://twitter.com/Chapters_HealthInstagram: https://www.instagram.com/chaptershealthsystemTiktok: @ChaptersHealthSystemPinterest: https://www.pinterest.com/chaptershealthIf you are a caregiver or passionate about chronic illness care and have a topic idea for the podcast or would like to provide feedback, feel free to reach out at socialmedia@chaptershealth.org.Follow us: Chapters Health System website: https://www.chaptershealth.org/Facebook : https://www.facebook.com/ChaptersHealth LinkedIn : https://www.linkedin.com/company/chapters-health-system/Twitter: https://twitter.com/Chapters_HealthInstagram: https://www.instagram.com/chaptershealthsystemTiktok: @ChaptersHealthSystemPinterest: https://www.pinterest.com/chaptershealth